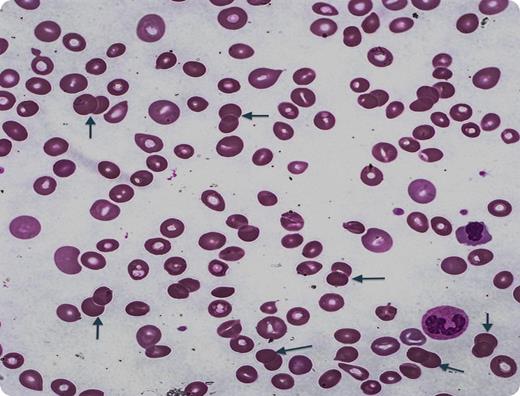
A 55-year-old woman presented with progressive fatigue, jaundice, and weight loss of 40 pounds. Physical examination revealed scleral icterus, axillary lymphadenopathy, and splenomegaly. Laboratory values showed a white blood cell count of 11 200/µL, hemoglobin 6.3 g/dL, hematocrit 18.3%, platelets 116 K/µL, haptoglobin <5.8 mg/dL, reticulocyte count 18.6%, mean corpuscular volume 131 fl, and indirect hyperbilirubinemia. Direct Coombs test was positive for immunoglobulin G (IgG) with no evidence for IgM. Peripheral smear revealed that 12% of discrete stained entities were doublets (arrows). Remarkably, there were no single spherocytes. Typically, normal smears show only rare doublets (<1%). There was no evidence of underlying lymphoproliferative disorder. Diagnosis was warm antibody autoimmune hemolytic anemia and thrombocytopenia (Evan syndrome). The patient relapsed after prednisone, rituximab, and splenectomy and eventually responded to azathioprine. With treatment, her mean corpuscular volume returned to normal along with disappearance of spherocytes. / Spherocytosis is a feature of autoimmune hemolytic anemias and results from partial phagocytosis of IgG/complement-coated erythrocytes. Doublet formation has only rarely been described previously. No triplets or larger aggregates were present is this case, but have been previously reported.

A 55-year-old woman presented with progressive fatigue, jaundice, and weight loss of 40 pounds. Physical examination revealed scleral icterus, axillary lymphadenopathy, and splenomegaly. Laboratory values showed a white blood cell count of 11 200/µL, hemoglobin 6.3 g/dL, hematocrit 18.3%, platelets 116 K/µL, haptoglobin <5.8 mg/dL, reticulocyte count 18.6%, mean corpuscular volume 131 fl, and indirect hyperbilirubinemia. Direct Coombs test was positive for immunoglobulin G (IgG) with no evidence for IgM. Peripheral smear revealed that 12% of discrete stained entities were doublets (arrows). Remarkably, there were no single spherocytes. Typically, normal smears show only rare doublets (<1%). There was no evidence of underlying lymphoproliferative disorder. Diagnosis was warm antibody autoimmune hemolytic anemia and thrombocytopenia (Evan syndrome). The patient relapsed after prednisone, rituximab, and splenectomy and eventually responded to azathioprine. With treatment, her mean corpuscular volume returned to normal along with disappearance of spherocytes.
Spherocytosis is a feature of autoimmune hemolytic anemias and results from partial phagocytosis of IgG/complement-coated erythrocytes. Doublet formation has only rarely been described previously. No triplets or larger aggregates were present is this case, but have been previously reported.
A 55-year-old woman presented with progressive fatigue, jaundice, and weight loss of 40 pounds. Physical examination revealed scleral icterus, axillary lymphadenopathy, and splenomegaly. Laboratory values showed a white blood cell count of 11 200/µL, hemoglobin 6.3 g/dL, hematocrit 18.3%, platelets 116 K/µL, haptoglobin <5.8 mg/dL, reticulocyte count 18.6%, mean corpuscular volume 131 fl, and indirect hyperbilirubinemia. Direct Coombs test was positive for immunoglobulin G (IgG) with no evidence for IgM. Peripheral smear revealed that 12% of discrete stained entities were doublets (arrows). Remarkably, there were no single spherocytes. Typically, normal smears show only rare doublets (<1%). There was no evidence of underlying lymphoproliferative disorder. Diagnosis was warm antibody autoimmune hemolytic anemia and thrombocytopenia (Evan syndrome). The patient relapsed after prednisone, rituximab, and splenectomy and eventually responded to azathioprine. With treatment, her mean corpuscular volume returned to normal along with disappearance of spherocytes.
Spherocytosis is a feature of autoimmune hemolytic anemias and results from partial phagocytosis of IgG/complement-coated erythrocytes. Doublet formation has only rarely been described previously. No triplets or larger aggregates were present is this case, but have been previously reported.
For additional images, visit the ASH IMAGE BANK, a reference and teaching tool that is continually updated with new atlas and case study images. For more information visit http://imagebank.hematology.org.
This feature is available to Subscribers Only
Sign In or Create an Account Close Modal